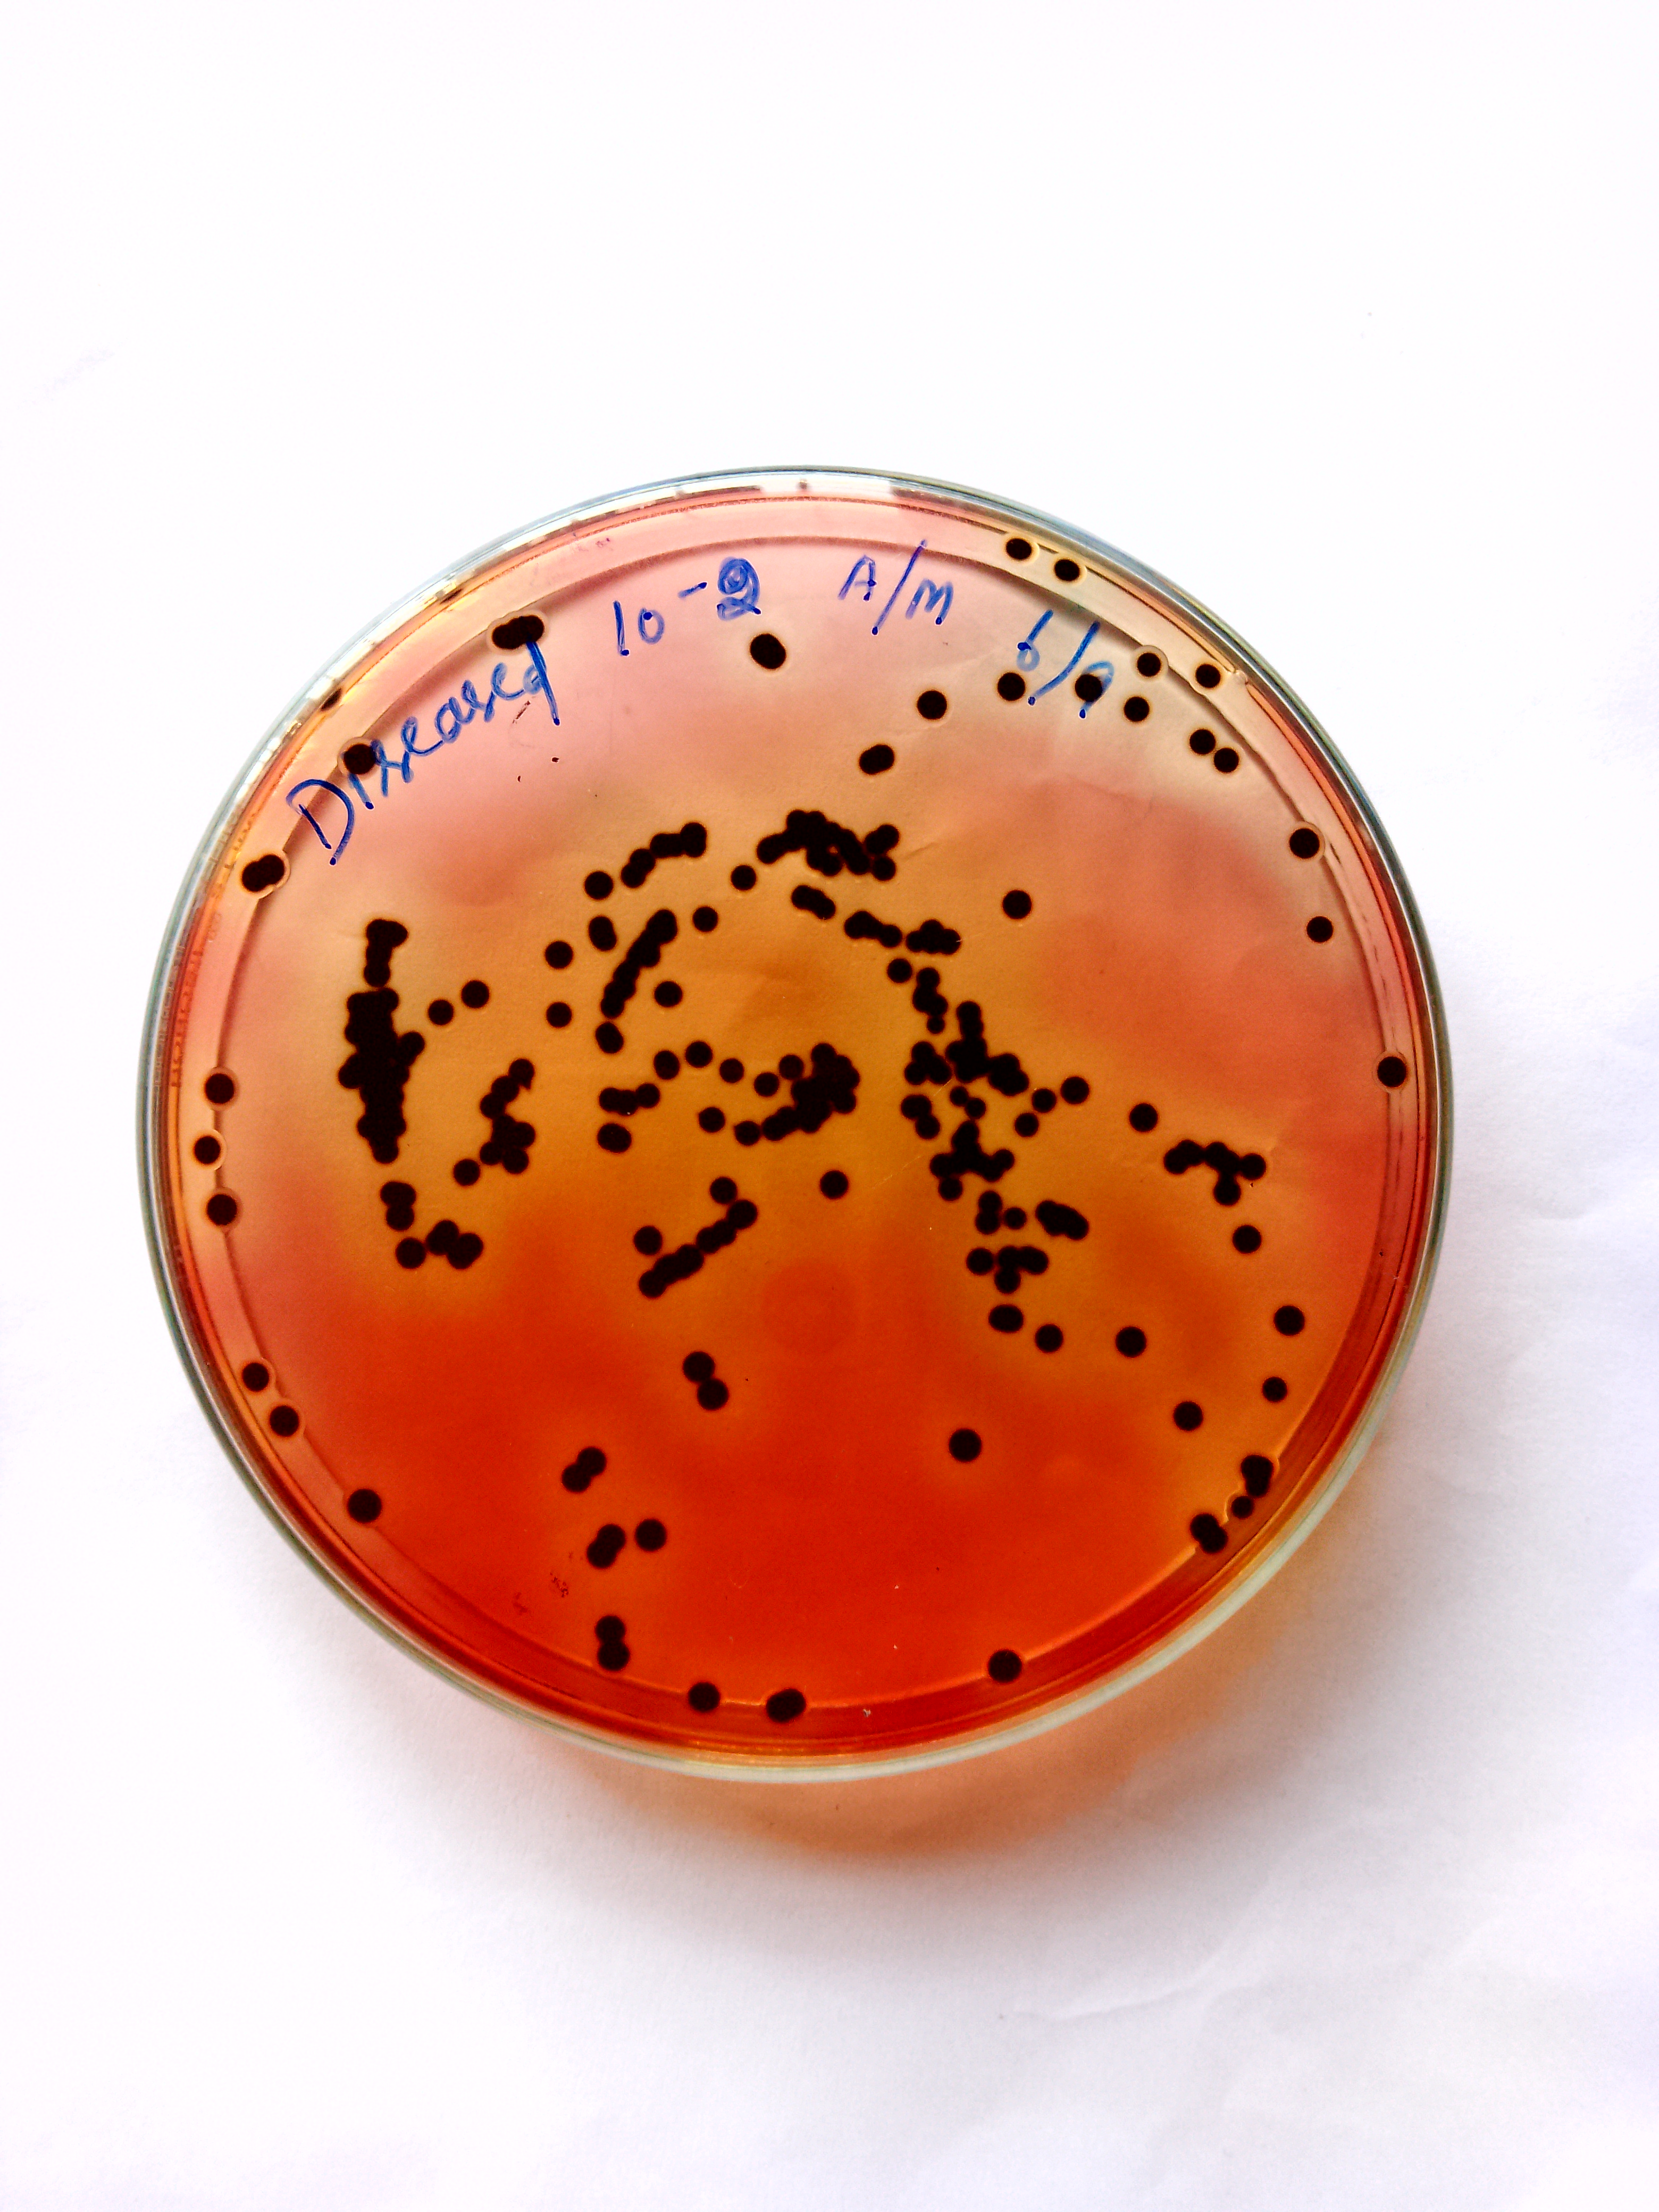
Expert

About Me
I'm a passionate student currently pursuing my master's in biotechnology at Alagappa University. I have top notch knowledge on the field of biotechnology, microbiology, molecular biology, immunology, industrial Biotechnology, research methodology, plant and animal biotechnology, cell biology and intellectual property rights, biosafety etc. My excellence in academics and my extraordinary communication skills make me a perfect candidate for the role.
Expert Location
Country:
India
City/Province:
Tamil Nadu
Language OF Delivery
English
Tamil
Teaches
Bachelor of Science
Academic Type
Academic Writer - 6 per Word
Education
Graduate
Passing Year: 2023
Bachelor of Science (BSC)
Grade
UndergraduateX11X1XIXVIII
Experience
Academic Experience : 4 YearsIndustry Experience : 0 Years
Job Profile : Student
Writing Type
ThesisResearch PaperDissertationEssay
Session Delivered Through
SkypeGoogle Hangouts
Online Whiteboard Experience
NA
Technology Experience
Microsoft WordMicrosoft ExcelMicrosoft Powerpoint
Tools Available
Headphones with a MicrophoneGood Internet Connection